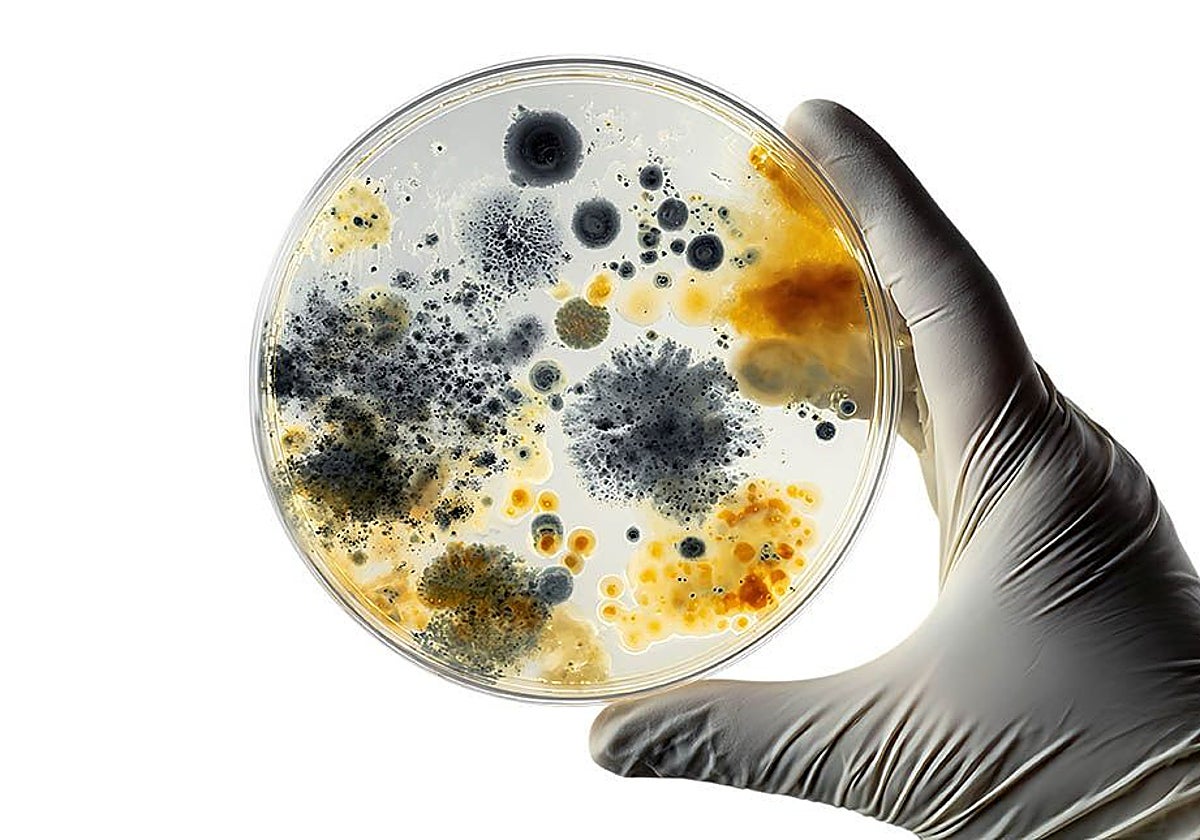
La maquinaria innovadora de la biotecnología se lanza a cambiar la industria de raíz

La maquinaria innovadora de la biotecnología se lanza a cambiar la industria de raíz
Empresas y centros tecnológicos españoles ya dan forma a algunas de las infinitas posibilidades que las soluciones a partir de organismos vivos y procesos biológicos naturales abren a la descarbonización de las fábricas
La irrupción de la IA da otra dimensión a la industria biotecnológica

Esta funcionalidad es sólo para registrados
Iniciar sesiónUn nuevo escenario se abre para la biotecnología blanca (también la hay roja aplicada a la salud o verde a la agricultura). Esta rama de la ciencia utiliza microorganismos y enzimas para optimizar y conseguir procesos industriales más respetuosos con el medio ambiente y fabricar ... nuevos productos mucho más sostenibles y eficientes. En la mayor parte de las ocasiones estas soluciones sustituyen a la química convencional, más contaminante, y con la que se han desarrollado muchos productos a partir del petróleo que están por todo nuestro alrededor. Con tecnología blanca ya se han fabricado materiales como bioplásticos biodegradables y biocombustibles como etanol; detergentes más eficientes con enzimas para eliminar manchas y que no contienen fosfatos; alimentos y cremas para la piel con probióticos que mejoran nuestra salud digestiva y la microbiota cutánea, respectivamente; fibras textiles hechas a base de bacterias y hongos que necesitan mucha menos agua para su producción...
La verdad es que el hombre conoce procesos biotecnológicos desde hace miles de años como la fermentación alcohólica del vino y la cerveza o para la elaboración del pan. Pero ahora con los objetivos que se han planteado de disminución de emisiones y la necesidad de reducir la huella de carbono en todas las actividades económicas junto a los grandes avances que se están dando en ingeniería genética, biología sintética y nuevas tecnologías de fermentación (que permiten diseñar microorganismos más eficientes, sostenibles y fabricarlos en biorreactores a gran escala), la biotecnología blanca emerge como la pieza clave para la transformación del sector industrial. «Es una de las herramientas más poderosas para dar forma a una economía más sostenible, eficiente y respetuosa con los límites del planeta», afirma Ion Arocena, director general de AseBio (la Asociación Española Bioempresas). Los analistas de Mordor Intelligence estiman que el mercado global de biotecnología blanca está valorado hoy día en 315.000 millones de dólares y se prevé que registre un crecimiento anual del 9,95% hasta 2029.
Oportunidad
Y en esta disciplina nuestro país tiene muchas oportunidades de crecer y desarrollar soluciones innovadoras. Según el informe de 2024 de AseBio contamos con 1.014 'biotech' puras, el 10% están dedicadas exclusivamente a esta biotecnología blanca, o también denominada industrial. «España con su ecosistema científico, su tejido empresarial e industrial y su capacidad de innovación tiene ante sí una oportunidad histórica: consolidarse como referente europeo en biotecnología industrial», asegura Arocena.
El sector cervecero le saca todo el jugo a sus residuos orgánicos
Charo BarrosoLa industria multiplica las vidas de sus desechos con propuestas que van desde el compostaje y el biogás a fabricar juguetes o levadura para el consumo humano
Por ahora, nuestro ecosistema en biotecnología blanca no se queda atrás. «Contamos con universidades, centros tecnológicos y empresas muy activas en bioprocesos. En los últimos años ha habido un fuerte impulso en el desarrollo de biopolímeros y compuestos bioactivos como antioxidantes, prebióticos... producidos con biotecnología blanca», dice Rosa Doménech, gerente de Biotecnología Industrial en el centro tecnológico Itene.
Pero no estamos en cabeza. «Aunque no lidera en volumen ni en capacidad frente a países como Alemania y Dinamarca, España puede llegar a convertirse en un actor estratégico, especialmente, si se consolidan políticas de apoyo y se refuerzan los marcos regulatorios y la financiación. Actualmente, los tres principales polos tecnológicos españoles se sitúan en Madrid, Cataluña y León donde se concentran empresas claves del sector de la biotecnología blanca, tanto españolas como multinacionales que apuestan por una presencia española. Entre ellas están DSM-Firmenich, Lonza, Zyrcular Foods, Lubrizol, Wacker León, CNTA, Cygyc Biocon, MOA FoodTech, etc...», cuenta Jörg Lindemann, director general de Wacker León. Esta empresa era antes ADL Biopharma (heredera de la antigua Antibióticos de León) y hoy es la filial de la compañía alemana Wackery. Ofrece servicios CDMO (Organización de Desarrollo y Fabricación por Contrato) en fermentación de precisión y cuenta con una de las instalaciones con mayor capacidad de fermentación de Europa.
Nuestras empresas de biotecnología blanca están en otros territorios. «Generan empleo cualificado y contribuyen al desarrollo rural ya que muchas de estas compañías cuentan con plantas de bioproducción y de bioprocesos en todo el territorio español como Salamanca, León o Cáceres», dice Arocena. Además el sector biotecnológico, en general, es tremendamente innovador. Es el cuarto sector de la economía con mayor intensidad de inversión en I+D en relación con la producción. En concreto, en 2023, fueron 1.282 millones de euros. «Y protege la mayor parte de sus innovaciones en el entorno europeo, con un 47% de las solicitudes registradas ante la Oficina Europea de Patentes y un número creciente de patentes compartidas entre distintas entidades», detalla Arocena.
Startups
Un ecosistema empresarial donde también las startups juegan un relevante papel acometiendo los retos más innovadores. Entre ellas están Cubiq Foods, Cocoon Bioscience, Biom, Catalyxx... «Las multinacionales tienen pulmón financiero para abordar proyectos muy complejos, pero están centradas en su portfolio de productos, no se suelen atrever a probar soluciones disruptivas de alto impacto y alto riesgo. Son las startup las que juegan ese papel», considera Javier Macía, director de Tecnología de BIOM BioInspired Materials.
El mercado global está valorado en 315.000 millones de dólares y crecerá casi un 10% anual
Hoy día hay ejemplos de procesos industriales y productos fabricados a partir de microorganismos y enzimas. Donde de forma más rápida y significativa se está desarrollando estas soluciones es «en el sector de la alimentación y bebidas por la alta demanda de productos 'clean label' (etiqueta limpia) que existe. La biotecnología blanca se aplica para la producción de aromas, probióticos, enzimas, vitaminas, proteínas alternativas, etc. También en cosmética y cuidado personal se están sustituyendo ingredientes sintéticos por activos naturales obtenidos por fermentación como antioxidantes, conservantes o fragancias, que ofrecen fórmulas más sostenibles y biodegradables», enumera Jörg Lindemann. Otro ámbito donde está tomando auge la biotecnología industrial es en el sector energético contribuyendo a fabricar biocombustibles como el etanol de segunda generación. Incluso se investiga las producción de biodiésel utilizando microalgas cultivadas en biorreactores. «En química -prosigue- la biotecnología blanca está permitiendo una sustitución progresiva de procesos petroquímicos en sectores como el textil, la automoción, el embalaje. Incluyendo materiales, solventes verdes, biopolímeros y adhesivos. Así mismo, aunque con una transición más lenta pero creciente, se encuentran el sector farmacéutico cuya transición resulta más gradual debido a la alta regulación y el sector de la agroindustria donde hay un creciente interés en biofertilizantes y biopesticidas».
Hoy la biotecnología industrial está en auge y tiene un prometedor futuro por delante sobre todo en Europa. «En un momento en el que la UE busca reforzar su autonomía estratégica, garantizar el acceso a materias primas críticas y atraer inversión industrial verde, la biotecnología se revela como un aliado imprescindible», considera Arocena.
Enzimas para lavar
La biotecnología blanca abre un infinito campo por explorar. «A partir de levadura en un biorreactor se ha conseguido fabricar azafrán, abaratando los costes de este condimento. Y la celulosa bacteriana, un material fabricado por bacterias, puede ser utilizado como alternativa al plástico. Es flexible, transparente e impermeable. Con hongos podemos producir industrialmente la albúmina (clara) del huevo, una proteína. Hay mucho mercado para la producción de proteínas a través de microorganismos, porque va a ser difícil mantener la productividad de la agricultura y ganadera y necesitamos una alimentación de calidad para una población en crecimiento», señala Javier Macía.
El biotecnológico es el cuarto sector de nuestra economía que más invirtió en I+D en 2023
Sirva como ejemplo los detergentes enzimáticos para entender los beneficios de la biotecnología industrial. En este caso, los microorganismos (principalmente bacterias y hongos) se introducen en avanzados biorreactores para fabricar enzimas a gran escala a través de la fermentación. Por ejemplo, las proteasas degradan las manchas de sangre y huevo y las lipasas descomponen las de aceite. Al incorporarlas a la formulación de los detergentes eliminan la suciedad a bajas temperaturas y sin fosfatos (un compuesto químico), reduciendo así el consumo de energía (calentar el agua es el mayor gasto energético en un lavado) y la contaminación. Además, las enzimas son fácilmente biodegradables y tienen un alto rendimiento a baja concentración en la fórmula del detergente, con lo cual también podemos ahorrar en envases. En los detergentes para vajillas, las enzimas disminuyen el tiempo del proceso de lavado y la cantidad de agua utilizada.
Ventajas
Hay que tener en cuenta una premisa de base: fabricar microorganismos o sus enzimas a temperatura ambiente tiene unos costes energéticos y medioambientales mucho menores que provocar reacciones químicas a alta temperaturas y presiones para obtener el mismo producto con las mismas funciones. Por ejemplo, producir microorganismos para mejorar la salud y la fertilidad de los suelos es mucho más barato y sostenible que fabricar fertilizantes con el mismo fin. «Cada nuevo proceso biotecnológico reduce la huella de carbono, aprovecha mejor los recursos naturales y genera productos más sostenibles y rentables», afirma Arocena. Además, muchas veces se utilizan residuos y subproductos de otras industrias (por ejemplo, restos de cítricos, agrícolas...) como materia prima para producir microorganismos, lo que supone también dar salida y valor a esos desperdicios. Otra ventaja es que los productos que se generan con biotecnología blanca suelen ser biodegradables o fáciles de reciclar o tratar.

Pero los microorganismo tienen también sus limitaciones. Es todo un reto mantenerles con vida y estables en un recipiente que puede estar almacenado durante meses hasta que ser utilizado. «Si nos los cuidas y alimentas, se mueren como cualquier ser vivo. En un laboratorio es sencillo mantener un microorganismo vivo, pero en un envase para su aplicación como fertilizante (por ejemplo), que se almacena durante tiempo hasta que se utiliza, puede ser que mueran. Hay que llevar al mercado soluciones con alta eficiencia porque si lo utiliza el consumidor y no da el resultado que esperaba, es muy difícil revertir esa confianza», apunta Javier Macía.
Proyectos
En España no faltan proyectos innovadores en biotecnología blanca que estén llevando a cabo startups y centros tecnológicos. Por ejemplo, BIOM BioInspired Materials nació en 2019 como una spin-off de la Universidad Pompeu Fabra de Barcelona. Hoy es una innovadora pyme dedicada al desarrollo de soluciones basadas en microorganismos para su uso en diversos sectores industriales, sobre todo agrícola. Y está a punto de sacar al mercado su primer producto. Se trata de una solución en la que pueden vivir los microorganismos durante ocho meses, sin morir ni crecer. «El agricultor puede conservar esta solución en un envase durante meses sin tener que cuidarla. Al utilizarla y mezclarla con agua deja de poseer esa propiedad bioestática y los microorganismos pueden nutrirse y reproducirse. Entonces, se convierte en un producto nutricional para el crecimiento de las plantas. O también puede tener un efecto de biocontrol contra las plagas. Se comercializará en el primer trimestre de 2026», cuenta Javier Macía.
Los principales polos son Cataluña, Madrid y León, también hay plantas en Cáceres y Salamanca
Los resultados en los ensayos experimentales han tenido un gran éxito. «Hemos conseguido multiplicar por dos la cosecha de trigo sin utilizar aditivos químicos», indica Macía.
Esta startup catalana también está trabajando en un compuesto para dar una solución a una enfermedad, conocida como el «ébola de los olivos» (nombre común de la bacteria Xylella fastidiosa), que ataca especialmente a esos árboles, a cítricos y también almendros «En el sur de Italia ha sido una catástrofe y ya ha llegado a Baleares. No existe ningún tratamiento para esta patología solo podar el árbol y los que le rodean. Estamos desarrollando un compuesto de metabolitos, fabricados por microorganismos. Junto con el Gobierno balear, estamos realizando ensayos con resultados positivos en olivos que se recuperan en un plazo de tiempo corto. Reduce la carga bacteriana», sostiene Macía.

Tienen otro producto en investigación: un inhibidor de infecciones bacterianas para piscifactorías. Mientras, también identifican microorganismos que puedan ofrecer propiedades atractivas para uso agrícola como alternativa a los fertilizantes. «Nuestra misión es producir microorganismos a escala industrial, preservarlos para conseguir su estabilidad a largo plazo y luego desarrollamos sus aplicaciones en diversos sectores industriales, aunque estamos centrados en agro ya que tiene muchas necesidades no resueltas», añade Macía.
El centro tecnológico Itene emplea residuos y subproductos de diferentes industrias como medio para hacer crecer los microorganismos. «Adaptamos los microorganismos y son capaces de alimentarse en este tipo de sustratos, que puede ser, por ejemplo, podredumbre de frutas. Ahí producen metabolitos que son los productos de alto valor y tienen diferentes aplicaciones. Así abaratamos costes y no nos hace falta comprar un sustrato comercial y caro ni materias primas vírgenes para alimentarlos, en su lugar usamos recursos como residuos y subproductos (desechos) de otras industrias, cuya gestión es además muy costosa. Nosotros introducimos todos esos restos, que no se utilizan, de nuevo en la cadena de producción contribuyendo así a la economía circular», cuenta Rosa Doménech, de Itene.
A través del proyecto Esencial 2024 los investigadores de Itene consiguieron grandes avances. Con procesos hidrolíticos y fermentativos aplicados a subproductos de la industria agroalimentaria (restos de vegetales, de melocotón, albaricoque...) lograron producir diversos elementos de gran valor añadido como ácido hialurónico para su aplicación en cosmética, «una industria que quiere fuentes naturales, no de origen animal, y sostenibles», matiza Doménech. También obtuvieron compuestos bioactivos con poder antioxidante (como la naringina, el ácido cafeico y la quercetina) para la industria nutracéutica. Y por último consiguieron probióticos para su incorporación a la fórmula de los detergentes. «En las lavadoras muchas veces aparece una especie de película que se debe limpiar. Los probióticos consiguen que no crezca esa película», matiza Doménech.

Alto valor añadido
Con subproductos agroforestales como la cascarilla del arroz, los sarmientos y orujos de la vid y las pieles de cítricos donde han crecido microorganismos Itene ha obtenido compuestos activos que potencian el crecimiento de las plantas y son una barrera frente a enfermedades fúngicas.
En el proyecto Valocel los equipos de Itene consiguieron optimizará la producción de celulosa bacteriana a partir de residuos de la naranja. «La celulosa bacteriana es un ingrediente de alto valor añadido que ahora se emplea como piel vegana y la producen microorganismos a partir de residuos vegetales. Se utiliza como agente espesante en cosmética y como excipiente en alimentación. O como recubrimiento para envases haciendo de barrera para aceites», comenta Doménech.
Nuevas soluciones a partir de organismos vivos y procesos biológicos naturales para entrar en la nueva era de la sostenibilidad.
Límite de sesiones alcanzadas
- El acceso al contenido Premium está abierto por cortesía del establecimiento donde te encuentras, pero ahora mismo hay demasiados usuarios conectados a la vez. Por favor, inténtalo pasados unos minutos.
Has superado el límite de sesiones
- Sólo puedes tener tres sesiones iniciadas a la vez. Hemos cerrado la sesión más antigua para que sigas navegando sin límites en el resto.
Esta funcionalidad es sólo para suscriptores
Suscribete
Esta funcionalidad es sólo para registrados
Iniciar sesiónEsta funcionalidad es sólo para suscriptores
Suscribete